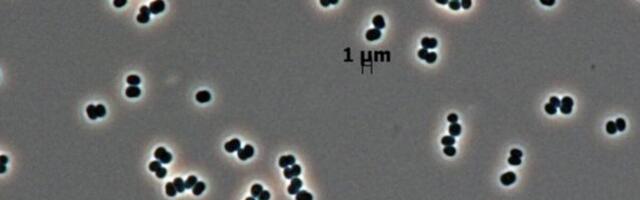
This Microbe ‘Plays Dead’ in NASA Clean Rooms, and We May Have Sent It to Mars

91 place 9
18 years ago, a sneaky bacteria infiltrated some of the cleanest places on Earth. Scientists finally know how.
A newsletter a day!
You may get 10 most important news around midday in daily newsletter. Press the button and we will send you the most important news only, no spam attached.
LIKE us on Facebook so you won't miss the most important news of the day!
An East Bay apartment complex has been bought at a price that's well below its prior value. Read more ›
0
A PG&E Corp. unit has bought a San Jose building in a move to bolster the utility's South Bay operations. Read more ›
0
A self-improvement app found that 42% of surveyed Gen Zers and millennials don't answer phone calls, while 58% script or rehearse conversations. Read more ›
0 newcommer
EV sales have been in a rut. Business Insider compiled a list of cars that have been discontinued or delayed this year. Read more ›
0 newcommer
Будучи преданным поклонником линейки ноутбуков Thinkpad от компании Lenovo, вот уже около 15 лет я использую и в работе, и в быту исключительно такие ноутбуки.К слову сказать, у меня до сих пор “в строю” ноутбуки Thinkpad X220, Thinkpad w520 и Thinkpad P50, которым всегда найдутся интересные задачи. И когда полтора года назад мне предоставилась возможность приобрести очередной топовый “финик”, после долгого и вдумчивого исследования предложений на рынке, я приобрёл ноутбук... Read more ›
0 newcommer
Sony's PSN login patent could make a DualSense part of the account access flow, but the bigger security test may still be PlayStation's account recovery process. Read more ›
0 newcommer
Мы не знаем, существуют ли в реальности гипотетические первичные чёрные дыры (ПЧД). Теоретически они должны были образоваться в самой ранней Вселенной, когда законы физики были совсем другими. У них не было звёзд-предшественников, они возникли в результате прямого коллапса плотно спрессованной субатомной материи. Теоретики задаются вопросом, могут ли ПЧД быть тёмной материей или её компонентом.Размеры этих гипотетических объектов остаются предметом споров, но, по некоторым оценкам, ПЧД находятся в диапазоне Read more ›
0 fresh
У меня было полторы сотни кросс-языковых фикстур, все тесты зелёные, и я был уверен, что мой Go-порт Yjs байт-в-байт совместим с оригиналом. Потом сравнил байты напрямую с канонической реализацией, и они разъехались: семантика сходится идеально, а на проводе документ толще.Юнит-тесты, roundtrip и даже конвергенц-тесты систематически пропускают баги совместимости, когда портируешь чужой бинарный формат на другой язык. Рабочий метод один: генерировать фикстуры из канона и требовать в CI побайтового совпадения Read more ›
0 fresh
KFC's strategy focuses on staying relevant across generations with new menu items, drinks, and designs, not just targeting Gen Z. Read more ›
0 fresh
What is the fintech, wider digital transformation and its contributions to economic development of the European nation of Moldova? Read more ›
0 fresh
Business Insider went inside a Ukrainian factory building ground robots for deadly missions soldiers can no longer risk. Read more ›
0 fresh
I invited cleaners and a chef from the startup Shift into my New York apartment. They worked for free — but recorded the process to train AI robots. Read more ›
0 fresh
Приблизительно в начале 2025-го года я решил попробовать 3D-печать и разработку печатных плат. Одна идея мотивировала меня на это — сделать свою игровую приставку. Но больше всего мне хотелось, чтобы она была полноценной и без колхоза. Мне кажется, на днях я частично достиг эту цель, когда сделал свою приставку, которую назвал Arduboy WOW.В этой статье расскажу о том, как я начал знакомство с Arduboy через симулятор, сделал первый вариант приставки... Read more ›
0 fresh
Allen Chen talks all things Fitbod, including what’s coming in the coming months. Read more ›
0 fresh
В последние годы купить новую видеокарту стало заметно сложнее и дороже. Одной из причин стал бурный рост систем искусственного интеллекта, для которых требуются огромные объемы вычислительных ресурсов. Крупные компании активно скупают графические ускорители для своих дата-центров, что влияет и на обычный рынок. В результате многие владельцы компьютеров не спешат с обновлением и продолжают использовать уже имеющееся железо или ищут недорогие варианты на вторичном рынке. В мире open-source эта ситуация приве Read more ›
0 fresh
OnePlus will unveil the OnePlus N6 on June 30 as the first smartphone in its new N Series. The brand already showed us the N6 in two colors and confirmed that it will pack an 8,000 mAh battery. Now, OnePlus has confirmed how fast the smartphone will charge. In a post on X, OnePlus India revealed that the N6 will support 45W SuperVOOC charging, enabling 1.7 hours of video playback... Read more ›
0 fresh
В этой статье мы решим задачи по расчётам основных параметров цепей, содержащих конденсатор C, индуктивность L, сопротивление R с учётом температурной зависимости R(T) и без неё. Во всех задачах примем, что сопротивление меняется по линейному закону R(T)=R0(1+αT) (это верно в ограниченном диапазоне температур от -50ºС до 200ºС). Температура измеряется в градусах Цельсия ºС.R0- сопротивление при 0ºС.Рассеянием тепла в окружающую среду и зависимостью теплоёмкости от температуры мы пренебрежём. Читать да Read more ›
0 fresh
I think this is easily one of the smartest desktop productivity tools around, and it's a steal at this price. Read more ›
0 fresh
Когда говорят о советской фантастике, обычно вспоминают Стругацких и их «Мир Полудня». Но концепцию развитого и гармоничного общества, где наука и технологии служат человеку, первым очертил другой автор, которого Стругацкие читали, с которым полемизировали и которому наследовали — Иван Ефремов. В трех романах о вселенной «Великого Кольца» он создал образ будущего, где знания не управляют людьми, а работают на них. Многие его идеи — что этика важнее чистого знания, что... Read more ›
0 fresh
Звучит как название сюжетной линии для сериала «Лост» или «Грань»? Суть в том, что наш мозг работает циклами, и сон/бодрствование это лишь один из многих примеров. Есть еще ультрадианные ритмы: 1,5 часа собран, в фокусе и продуктивности, а потом голова ватная, ноль концентрации, надо бы передохнуть. То есть сама природа циклов – это нечто привычно и естественное, что мы ощущаем каждый день. Но вот теперь открыта группа нейронов, которые буквально... Read more ›
0 fresh
People's daily steps might drop after starting a GLP-1 prescription, new research suggests. Read more ›
0
The Department of Justice has no issue with Paramount getting what it wants, but state AGs and overseas regulators still have concerns. Read more ›
0
An AI startup founder is using Claude to make a GTA ripoff. Read more ›
0
Kerry helped bring Tinker Bell to life for 'Peter Pan,' and the fairy's gone one to become one of Disney's most enduring mascots. Read more ›
0
The 'Monuments of Triumph' update lets 'Destiny 2' go out on its own terms, tie up some threads, and lay crumbs for a hopeful return. Read more ›
0
New mutants and old friends await when 'X-Men '97' returns for season two in July. Read more ›
0
Crypto platforms may not be the best options for getting IPO allocations. Read more ›
0
The report indicates that grassroots activity in opposition to data centers is spiking dramatically. Read more ›
0
Most popular sources
|
|
0% |
|
|
0% |
|
|
0% |
|
|
0% |
|
|
0% |
| View sources » | |
LIKE us on Facebook so you won't miss the most important news of the day!
20.06.2026 04:51
Last update: 04:45 EDT.
News rating updated: 11:42.
What is Times42?
Times42 brings you the most popular news from tech news portals in real-time chart.
Read about us in FAQ section.